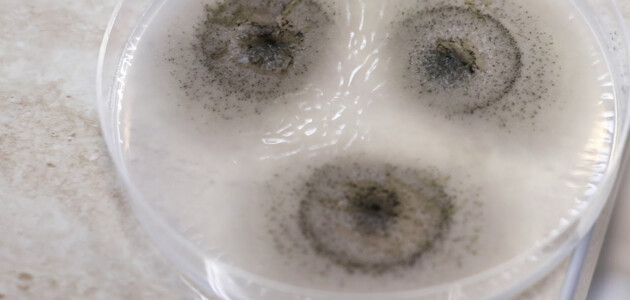
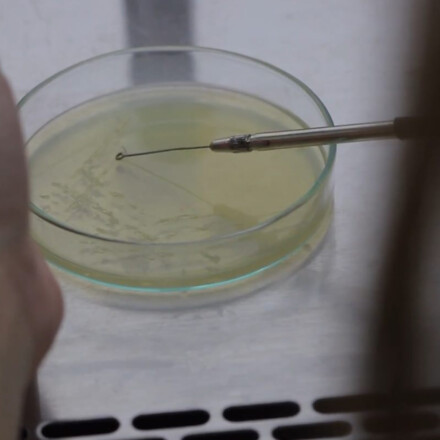

O nás
Fakulta biotechnológie a potravinárstva SPU v Nitre patrí medzi najlepšie fakulty v SR so zameraním na potravinárstvo, biotechnológiu a biológiu. Naším cieľom je vzdelávanie a vychovávanie vysokokvalifikovaných odborníkov, ktorí si bez problémov nachádzajú uplatnenie v praxi na Slovensku aj v zahraničí.
Fakulta organizuje vzdelávanie v akreditovanom trojstupňovom štúdiu (bakalárske, inžinierske, doktorandské). V trojročnom bakalárskom a dvojročnom inžinierskom štúdiu je vzdelávací program zložený z povinných základných teoretických a odborných predmetov a voliteľných predmetov zvoleného študijného odboru. Tento systém zabezpečuje flexibilitu štúdia a prispieva autoprofilácii poslucháča. Okrem toho spolupracujeme so zahraničnými inštitúciami na rozmanitých medzinárodných projektoch.
Uplatnenie
Naša fakulta je hrdá na našich absolventov, ktorí nachádzajú široké uplatnenie vo vyštudovanom odbore. Na fakulte pripravujeme absolventov na prax, o ktorých majú firmy reálny záujem. Absolvent sa na základe vyštudovaného programu môže uplatniť napríklad v nasledovných oblastiach: potravinárske podniky, biotechnologické podniky, sklady, distribučné a logistické centrá, maloobchodné a veľkoobchodné prevádzky, výskumné a šľachtiteľské pracoviská, laboratóriá, orgány úradnej kontroly potravín, štátne inštitúcie, inšpekčné orgány, certifikačné orgány, poradenské firmy a ďalšie.
Medzi najčastejšie pracovné pozície našich absolventov patria:
- vedúci výroby
- technológ výroby
- manažér kvality a bezpečnosti potravín
- manažér v maloobchode v reťazcoch
- inšpektor
- audítor
- úradník
- laborant
- výskumný pracovník
- vývojár výrobkov
- kontrolór kvality
- prevádzkar
- vedúci stravovacích prevádzok
Poď k nám → vyber si zdravé štúdium 🌱
Kde nás nájdeš
Fakulta biotechnológie a potravinárstva
Slovenská poľnohospodárska univerzita v Nitre
Tr. A. Hlinku 2
949 76 Nitra
Prihlášky a prijímačky
Bakalárske štúdium
- Termín podania prihlášky (1.kolo): 30. 4. 2026
- Termín podania prihlášky (2.kolo): 15. 7. 2026
- Bez prijímacej skúšky
Prihláška sa podáva elektronickou alebo papierovou formou.
Základnou podmienkou prijatia je úplné stredné vzdelanie alebo úplné stredné odborné vzdelanie a dovŕšenie 18 roku veku do dňa zápisu na štúdium.
Prijímacie konanie sa uskutoční formou prijímacieho pohovoru.
Uchádzači o štúdium budú prijímaní na základe výsledkov dosiahnutých počas štúdia na strednej škole a na maturitnej skúške.
Ak splní podmienky prijatia väčší počet uchádzačov, prijatí budú tí uchádzači, ktorí preukážu najvyššiu mieru schopností na štúdium podľa podmienok určených fakultou, pričom zvýhodnení budú študenti, ktorí v priebehu stredoškolského štúdia absolvovali predmety chémia a biológia.
Inžinierske štúdium
- Termín podania prihlášok: 15. 7. 2026
- Bez prijímacej skúšky
Doktorandské štúdium
- Termín podania prihlášky: 29. 5. 2026
- Prijímacia skúška: 10. 6. 2026
Poplatok za prijímacie konanie: 40€ (50€ pre PhD.)
Aktuality
Doplňujúce informácie
Na fakulte venujeme dôraz moderným trendom, ktoré aplikujeme do vzdelávacieho procesu. Fakulta spolupracuje s množstvom potravinárskych a biotechnologických firiem, maloobchodných reťazcov, laboratórií, štátnych inštitúcií, orgánov úradnej kontroly potravín, hotelových a reštauračných zariadení, zariadeniami sociálnych služieb. Naši študenti absolvujú povinnú prax u našich zmluvných partnerov alebo u firiem, ktoré si sami vyberú.
Na fakulte pôsobia tri ústavy: Ústav aplikovanej biológie, Ústav biotechnológie, Ústav potravinárstva. Jednotlivé ústavy majú viaceré pracoviská, ktoré zabezpečujú vzdelávací proces a výskum.
Fakulta disponuje moderným, špičkovým laboratórnym vybavením. Zaoberáme sa výskumom orientovaným na prax a pravidelne získavame granty na jeho realizáciu. Výsledky našej vedeckej činnosti sú publikované v prestížnych vedeckých časopisoch. Zabezpečujeme transfer nových poznatkov z vlastnej tvorivej činnosti do vzdelávacieho procesu.
Fakulta podporuje študentov v zahraničných pobytoch, pre tieto účely môžu študenti využívať viaceré programy mobilít ako sú ERASMUS, CEEPUS a Národný štipendijný program.
Fakulta ponúka široké možnosti spoločenského, kultúrneho a športového vyžitia, angažovanie sa študentov v študentskom spolku Pasteur. Študenti majú k dispozícii opravené internáty. Môžu sa ubytovať v niektorom z piatich študentských domovoch, ktoré sú priamo v areály SPU v Nitre alebo jeho tesnej blízkosti.
Chceš sa o našej a možno raz aj tvojej práci dozvedieť viac? Pusti si labákový podkast! ⚗️
Kontakt
Fakulta biotechnológie a potravinárstva
Slovenská poľnohospodárska univerzita v Nitre
Tr. A. Hlinku 2
949 76 Nitra